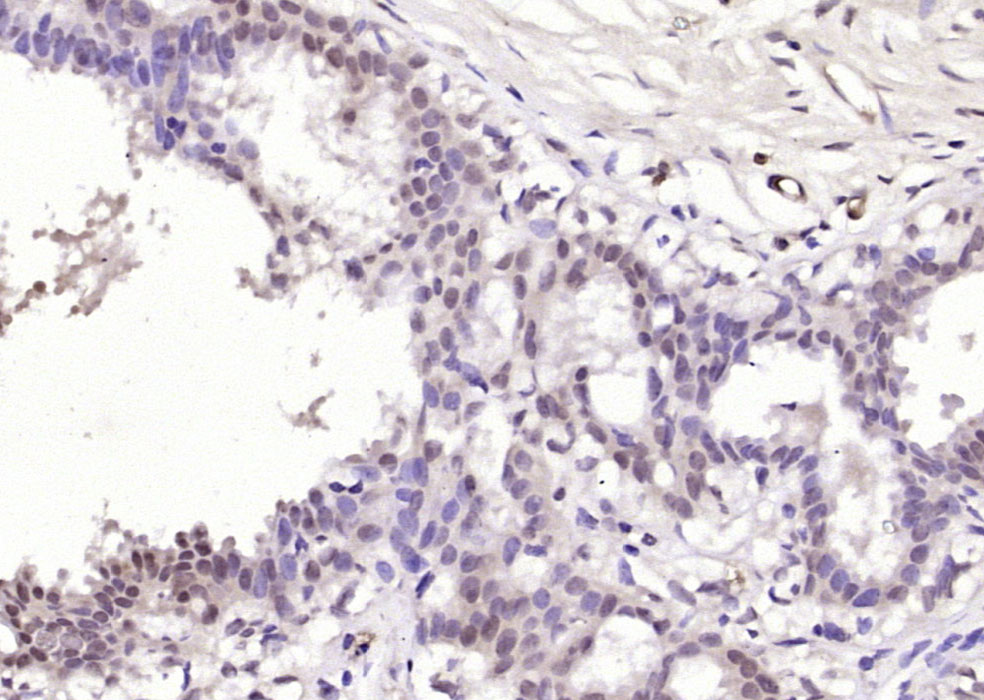
AMIGO2 Rabbit pAb(bs-11450R)-5

Tissue/cell: mouse placenta tissue; 4% Paraformaldehyde-fixed and paraffin-embedded;
Antigen retrieval: citrate buffer ( 0.01M, pH 6.0 ), Boiling bathing for 15min; Block endogenous peroxidase by 3% Hydrogen peroxide for 30min; Blocking buffer (normal goat serum,C-0005) at 37℃ for 20 min;
Incubation: Anti-AMIGO2 Polyclonal Antibody, Unconjugated(bs-11450R) 1:200, overnight at 4°C, followed by conjugation to the secondary antibody(SP-0023) and DAB(C-0010) staining
相关产品推荐更多 >

Corin Rabbit pAb, PerCP-Cy5.5 conjugated(bs-7685R-PerCP-Cy5.5)-100ul
¥2980
E2F1 Rabbit pAb, PerCP-Cy5.5 conjugated(bs-23185R-PerCP-Cy5.5)-100ul
¥2980
NOL4 Rabbit pAb(bs-19310R)-50ul/100ul/200ul
¥1180
TYROBP Rabbit pAb, PE-Cy5.5 conjugated(bs-12630R-PE-Cy5.5)-100ul
¥2980
GADD45A Rabbit pAb, APC-Cy5.5 conjugated(bs-1360R-APC-Cy5.5)-100ul
¥2980
万千商家帮你免费找货
0 人在求购买到急需产品
- 详细信息
- 文献和实验
- 技术资料
- 应用范围:
产品信息以Bioss网站为准
- 规格:
50ul/100ul/200ul
| 规格: | 50ul | 产品价格: | ¥1180.0 |
|---|---|---|---|
| 规格: | 100ul | 产品价格: | ¥1980.0 |
| 规格: | 200ul | 产品价格: | ¥2800.0 |
| 产品编号 | bs-11450R |
| 英文名称 | AMIGO2 Rabbit pAb |
| 中文名称 | 粘附分子IgG样结构域蛋白2抗体 |
| 英文别名 | Adhesion molecule with Ig like domain 2; ALI 1; ALI1; Alivin 1; Alivin-1; Alivin1; AMIGO 2; Amphoterin induced gene 2; Amphoterin induced protein 2; DEGA; AMGO2_HUMAN; AMIGO-2; Amigo2; Amphoterin induced protein 2; Amphoterin-induced protein 2; Differentially expressed in gastric adenocarcinoma; Differentially expressed in gastric adenocarcinomas; Transmembrane protein AMIGO 2; Transmembrane protein AMIGO2. |
| 产品应用 | WB=1:500-2000, IHC-P=1:100-500, IHC-F=1:100-500, IF=1:100-500 Not yet tested in other applications. |
| 交叉反应 | Human, Mouse, Rat (Dog, Pig, Cow, Horse, Sheep) |
| 抗体来源 | Rabbit |
| 免疫原 | KLH conjugated synthetic peptide derived from human AMIGO2 |
| 亚型 | IgG |
| 性状 | Liquid |
| 纯化方法 | affinity purified by Protein A |
| 克隆类型 | Polyclonal |
| 理论分子量 | 54 kDa |
| 浓度 | 1mg/ml |
| 储存液 | 0.01M TBS (pH7.4) with 1% BSA, 0.02% Proclin300 and 50% Glycerol. |
| 研究领域 | Neuroscience > Neurology process > Growth and Development > Axonal Guidance Proteins |
| 亚基 | Binds itself as well as AMIGO1 and AMIGO3 (By similarity). |
| 亚细胞定位 | Cell membrane; Single-pass type I membrane protein. Nucleus. Note: Associated with nucleus as well as plasma membrane. Restricted to somata of cerebellar as well as hippocampal neurons By |
| 组织特异性 | Highest levels in breast, ovary, cervix, and uterus. Lower levels in lung, colon, and rectum. Differentially expressed in 56% of thyroid, 57% of pancreatic and 45% of stomach cancers. |
| 相似性 | Belongs to the immunoglobulin superfamily. AMIGO family. Contains 1 Ig-like C2-type (immunoglobulin-like) domain. Contains 6 LRR (leucine-rich) repeats. Contains 1 LRRCT domain. Contains 1 LRRNT domain. |
| 功能 | A novel primary response gene, AMIGO2, is an activity-dependent gene and promotes survival of neurons. Sequence analyses reveal that rat, mouse, and human AMIGO2 proteins contain seven leucine-rich repeats, one IgC2-like loop and a transmembrane domain, and display homology to Kek and Trk families. Results suggest that expression of ali1 promotes depolarization-dependent survival of the granule neuron. Mouse AMIGO2 was mapped to a locus approximately 55.3 cm from the centromere on chromosome 15 that is syntenic to positional candidate loci for familial Alzheimer's disease type 5 and Parkinson's disease 8 on human chromosome 12. |
| 保存条件 | Shipped at 4℃. Store at -20℃ for one year. Avoid repeated freeze/thaw cycles. |
| 注意事项 | This product as supplied is intended for research use only, not for use in human, therapeutic or diagnostic applications. |
| 背景资料 | The amphoterin-induced gene and ORF (AMIGO) family of proteins consists of AMIGO-1, AMIGO-2 and AMIGO-3. All three members are single pass type I membrane proteins that contain several leucine-rich repeats, one IgG domain, and a transmembrane domain. The AMIGO proteins are specifically expressed on fiber tracts of neuronal tissues and participate in their formation. The AMIGO proteins can form complexes with each other, but can also bind itself. AMIGO-1, also designated Alivin-2, promotes growth and fasciculation of neurites and plays a role in myelination and fasciculation of developing neural axons. In cerebellar neurons, AMIGO-2 (Alivin-1) is crucial for depolarization-dependent survival. Similar to AMIGO-1 and AMIGO-2, AMIGO-3 (Alivin-3) plays a role in homophilic and/or heterophilic cell-cell interaction and signal transduction. |
| 应用 | 推荐稀释比例 |
| {WB} | {1:500-2000} |
| {IHC-P} | {1:100-500} |
| {IHC-F} | {1:100-500} |
| {IF} | {1:100-500} |


Sample:
Hela(Human) Cell Lysate at 30 ug
Primary: Anti- AMIGO2 (bs-11450R) at 1/1000 dilution
Secondary: IRDye800CW Goat Anti-Rabbit IgG at 1/20000 dilution
Predicted band size: 54 kD
Observed band size: 54 kD
Hela(Human) Cell Lysate at 30 ug
Primary: Anti- AMIGO2 (bs-11450R) at 1/1000 dilution
Secondary: IRDye800CW Goat Anti-Rabbit IgG at 1/20000 dilution
Predicted band size: 54 kD
Observed band size: 54 kD
Paraformaldehyde-fixed, paraffin embedded (human breast); Antigen retrieval by boiling in sodium citrate buffer (pH6.0) for 15min; Block endogenous peroxidase by 3% hydrogen peroxide for 20 minutes; Blocking buffer (normal goat serum) at 37°C for 30min; Antibody incubation with (AMIGO2) Polyclonal Antibody, Unconjugated (bs-11450R) at 1:200 overnight at 4°C, followed by operating according to SP Kit(Rabbit) (sp-0023) instructionsand DAB staining.

Paraformaldehyde-fixed, paraffin embedded (rat small intestine); Antigen retrieval by boiling in sodium citrate buffer (pH6.0) for 15min; Block endogenous peroxidase by 3% hydrogen peroxide for 20 minutes; Blocking buffer (normal goat serum) at 37°C for 30min; Antibody incubation with (AMIGO2) Polyclonal Antibody, Unconjugated (bs-11450R) at 1:200 overnight at 4°C, followed by operating according to SP Kit(Rabbit) (sp-0023) instructionsand DAB staining.

Paraformaldehyde-fixed, paraffin embedded (mouse small intestine); Antigen retrieval by boiling in sodium citrate buffer (pH6.0) for 15min; Block endogenous peroxidase by 3% hydrogen peroxide for 20 minutes; Blocking buffer (normal goat serum) at 37°C for 30min; Antibody incubation with (AMIGO2) Polyclonal Antibody, Unconjugated (bs-11450R) at 1:200 overnight at 4°C, followed by operating according to SP Kit(Rabbit) (sp-0023) instructionsand DAB staining.
风险提示:丁香通仅作为第三方平台,为商家信息发布提供平台空间。用户咨询产品时请注意保护个人信息及财产安全,合理判断,谨慎选购商品,商家和用户对交易行为负责。对于医疗器械类产品,请先查证核实企业经营资质和医疗器械产品注册证情况。
文献和实验该产品被引用文献
[IF={{ 5.923 }}] {Kirsten Hülskötter. et al. Tamoxifen Application Is Associated with Transiently Increased Loss of Hippocampal Neurons following Virus Infection. Int J Mol Sci. 2021 Jan;22(16):8486} {IHC} {Mouse}
技术资料暂无技术资料 索取技术资料
文献支持
AMIGO2 Rabbit pAb(bs-11450R)-50ul/100ul/200ul
¥1180 - 2800





